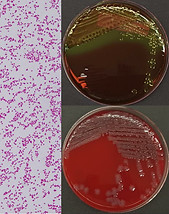

The Rubin Lab

Dr. Joe Rubin
Welcome to the Rubin Lab!
The Rubin Lab is focused on the theme of antimicrobial resistance. Before the introduction of penicillin as a drug in the early 1940's physicians were largely powerless to bacterial infections; antibiotics were arguably the most important advance in medicine of the 20th century. Unfortunately, the extraordinary ability of bacteria to adapt led to the emergence of antibiotic resistance. Resistant organisms, commonly called 'superbugs', are increasingly encountered in both human and veterinary medicine and are threatening the ability of physicians and veterinarians to treat their patients. Many of these bacteria are well adapted to a wide variety of hosts, and easily transmit between humans and animals making antibiotic resistance a problem for both human and veterinary medicine.
We are located in the Department of Veterinary Microbiology in the Western College of Veterinary Medicine on the University of Saskatchewan campus located in beautiful Saskatoon, Canada. Although our group is located within a vet school, our research is not limited to domestic animals; we work with bacteria from all sorts of interesting places including wildlife, food products and even people!